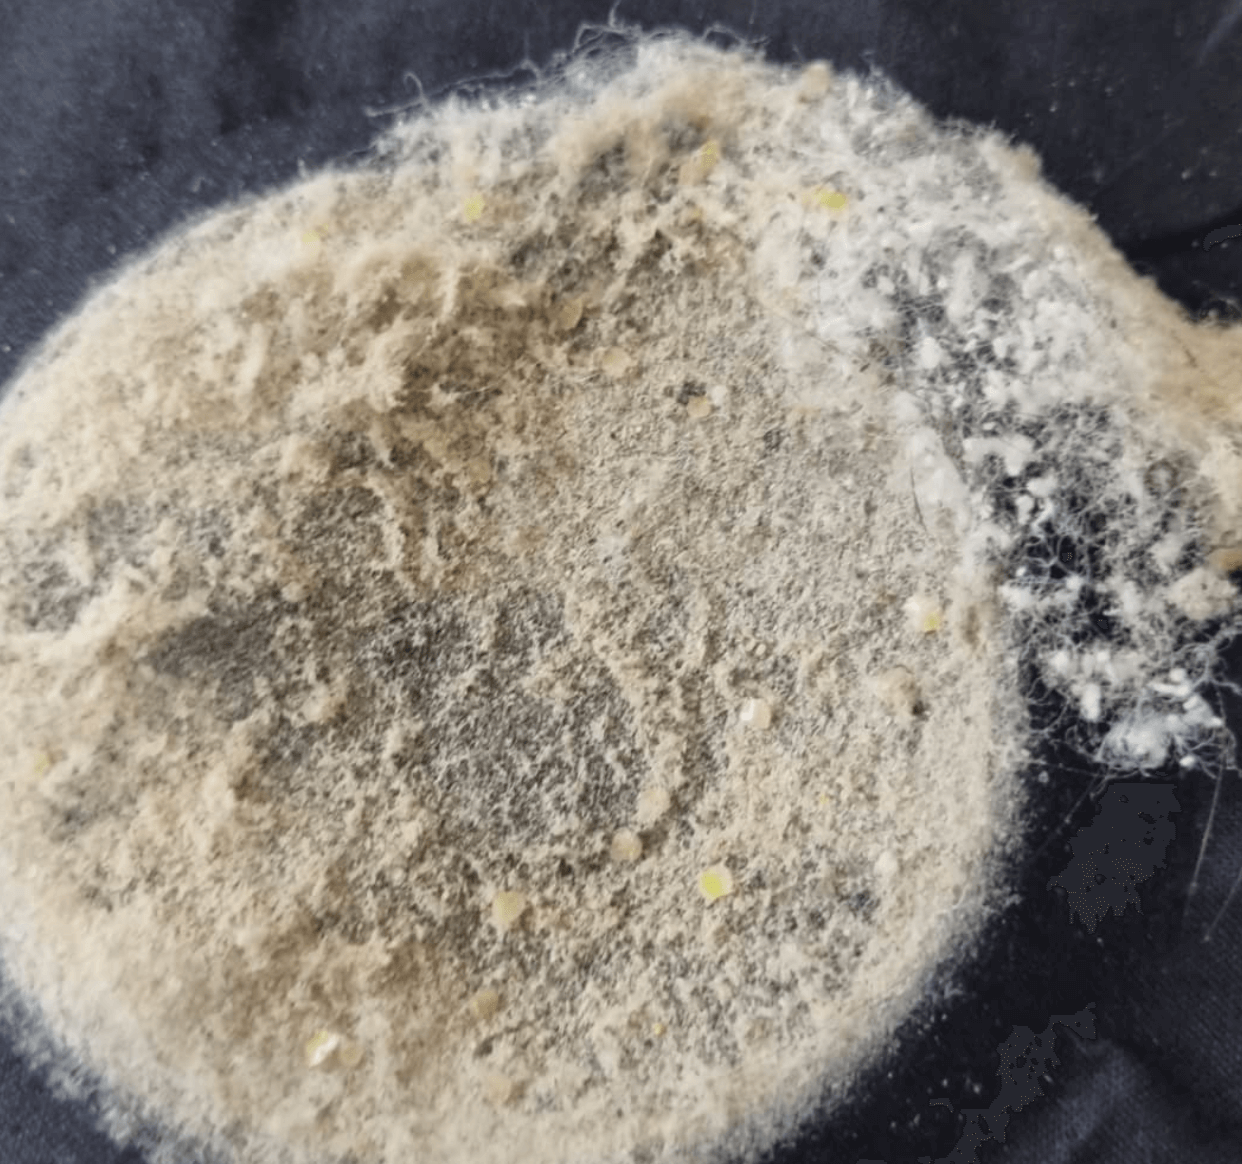

2TV 생생정보 2022년 2월 21일 (월) 방송리뷰
1491회 <집먼지진드기> 청소업체 정보
안녕하세요 날이 조금씩 풀리면서 봄철 알레르기의 주범인 집먼지진드기를 잡는 방법을 소개 했습니다. 봄이 오면 알러지와 비염으로 고생하는 분들이 꽤 많이 계실 것 같아요! 때문에 환절기 감기도 꼭 주의 하셔야 겠습니다. 이런 알러지를 예방하기 위해서는 집에서 자주자주 환기를 시켜 주는게 중요하답니다. 이불은 꼭 햇빛에 한번씩 소독을 해주는것도 좋아요. 요즘은 제품이 잘 나와서 제품을 적절하게 사용하는것도 좋을 것 같네요. 오늘 방송에 소개된 청소업체를 통해 봄철 청소를 맡겨보는 것도 좋을 것 같습니다.




오늘 방송을 통해 소개된 봄철 집먼지진드기 청소업체에 대한 정보는 아래 기재된 내용을 확인해 주세요.
비치움
1899-9373
이번주 많이 본 글 추천
생생정보 힙하게놀자 충남 보령 굴구이 굴찜 파는곳 위치 정보 후기 가격 메뉴 촬영지 식당 주소
2TV 생생정보 2022년 2월 21일 (월) 방송리뷰 1491회 <채현의 ‘힙’하게 놀자!> 천북굴단지 식당 정보 안녕하세요. 오늘 생생정보 <채현의 ‘힙’하게 놀자!> 코너에서는 충남 보령에 방문했습니다.
sports.flextube.co.kr
오늘저녁 소문듣고 왔습니다 함평 한우 생고기 육회 낙지 홍어 전문점 식당 정보 위치 주소 촬영
생방송 오늘저녁 2022년 2월 21일 (월) 방송리뷰 1725회 <소문 듣고 왔습니다> 한우식당 정보 오늘 저녁 6시5분 생방송 오늘저녁 방송 <소문 듣고 왔습니다> 코너에서는 전남 함평에 소문난 곳을 방문
sports.flextube.co.kr
'방송정보' 카테고리의 다른 글
| 줄서는 식당 6회 강남역 쌀국수 소곱창 쌀국수 돼지갈비 튀김 파는곳 촬영지 식당 위치 메뉴 후기 가격 공개 (0) | 2022.02.21 |
|---|---|
| 생생정보 신의한수 맛의결정타 육개장 파는곳 약암 200그릇 한정 판매 하는곳 촬영지 정보 위치 후기 가격 메뉴 어디? (0) | 2022.02.21 |
| 생생정보 힙하게놀자 충남 보령 굴구이 굴찜 파는곳 위치 정보 후기 가격 메뉴 촬영지 식당 주소 굴 택배문의 전화번호 구매처 공개 (0) | 2022.02.21 |
| 6시 내고향 보령 낙지 파는곳 수산시장 위치 주소 정보 수산업자 전화번호 택배문의 주문하기 (0) | 2022.02.21 |
| 6시 내고향 여수 갓김치 갓피클 파는곳 위치 식당 택배문의 온라인 홈페이지 주문하기 후기 가격 촬영지 어디? (0) | 2022.02.21 |

댓글